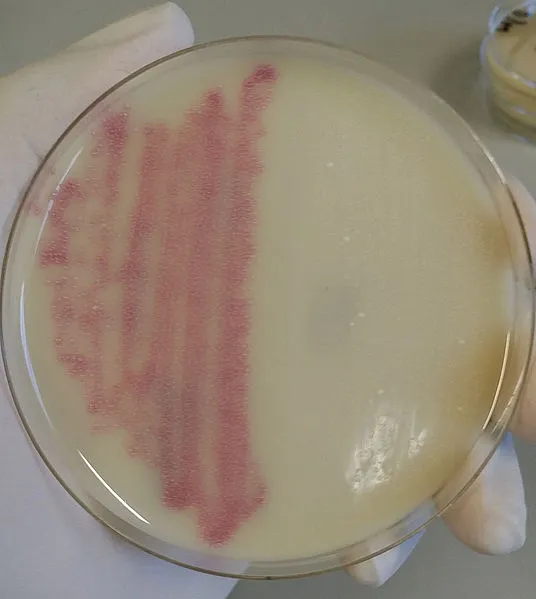

發(fā)布時(shí)間:2024-04-02 發(fā)布作者:上海通蔚生物
培養(yǎng)基是營(yíng)養(yǎng)豐富的液體或凝膠,支持微生物的生長(zhǎng)。微生物無處不在,生長(zhǎng)在不同的棲息地,需要不同的營(yíng)養(yǎng)。因此,我們不能期望在同一培養(yǎng)基中培養(yǎng)不同的微生物。根據(jù)微生物的需要,營(yíng)養(yǎng)物質(zhì)的組成和濃度會(huì)有所不同。因此,營(yíng)養(yǎng)培養(yǎng)基被分為不同的類型。
圖1 培養(yǎng)基類型
實(shí)驗(yàn)室培養(yǎng)微生物的主要目的是分離和研究微生物。在實(shí)驗(yàn)室中,我們從混合群體中分離出純培養(yǎng)物,并探索它們生產(chǎn)生物產(chǎn)品和解決環(huán)境挑戰(zhàn)的能力。培養(yǎng)微生物也是診斷實(shí)驗(yàn)室診斷疾病、研究致病性和開發(fā)疫苗的重要步驟。
培養(yǎng)基一般分類為形態(tài)、成分、用途分類。
形態(tài)分為:液體培養(yǎng)基、固體培養(yǎng)基、半固體培養(yǎng)基。
成分分為:天然培養(yǎng)基、合成培養(yǎng)基。
用途分為:基礎(chǔ)培養(yǎng)基、營(yíng)養(yǎng)培養(yǎng)基、選擇性培養(yǎng)基、厭氧培養(yǎng)基、富集培養(yǎng)基、差異培養(yǎng)基。
根據(jù)形態(tài)分類培養(yǎng)基可分為:
1、固體培養(yǎng)基——固體培養(yǎng)基是使用瓊脂等固化劑制備的。在固體培養(yǎng)基中,瓊脂濃度在1.5%至2%范圍內(nèi)。固體培養(yǎng)基提供微生物生長(zhǎng)的表面。微生物以菌落的形式在表面生長(zhǎng)。
2、半固體培養(yǎng)基——這種培養(yǎng)基也是通過添加濃度較低的固化劑來制備的。瓊脂通常添加量在0.5%左右。半固體培養(yǎng)基具有中等稠度。此類培養(yǎng)基主要用于培養(yǎng)微需氧微生物和研究細(xì)菌運(yùn)動(dòng)性
3、液體培養(yǎng)基——液體培養(yǎng)基也稱為肉湯培養(yǎng)。其中不添加固化劑。液體培養(yǎng)基的目的是以懸浮液的形式培養(yǎng)微生物并進(jìn)行各種生化測(cè)試。在發(fā)酵工業(yè)中,肉湯培養(yǎng)主要用于生物制品的生產(chǎn)。
根據(jù)成分培養(yǎng)基可分為:
1、天然培養(yǎng)基——含有不完全明了化學(xué)成分的天然物質(zhì)。如蛋白胨、牛肉膏(粉)、肉浸液、玉米漿、血液、馬鈴薯等。用此類材料配成的培養(yǎng)基很難做到不同批號(hào)之間質(zhì)量的穩(wěn)定一致,因此在選用原料時(shí)務(wù)必注明其商品名稱、生產(chǎn)廠家及批號(hào),對(duì)不同來源的原料應(yīng)先做小樣試驗(yàn)。此種培養(yǎng)基成本較低,細(xì)菌繁殖較好,一般細(xì)菌培養(yǎng)以選用天然培養(yǎng)基為主。
2、合成培養(yǎng)基—— 由已知化學(xué)成分的營(yíng)養(yǎng)物質(zhì)組成的培養(yǎng)基。根據(jù)微生物對(duì)營(yíng)養(yǎng)要求的不同,可完全由無機(jī)鹽或化合物組成,如:氨基酸、糖、嘌呤、嘧啶、維生素等,其組成成分已知,只要嚴(yán)格操作,各批次間質(zhì)量可做到穩(wěn)定一致。此培養(yǎng)基可用來檢測(cè)某種營(yíng)養(yǎng)物或藥物對(duì)微生物代謝的影響。組織細(xì)胞培養(yǎng)液均屬合成培養(yǎng)基。合成培養(yǎng)基的成本較高,其價(jià)格相當(dāng)于同類天然培養(yǎng)基的幾倍以至于幾十倍。只含幾種無機(jī)鹽的合成培養(yǎng)基,僅適用于自養(yǎng)菌的培養(yǎng),如培養(yǎng)亞硝化細(xì)菌、氧化硫桿菌等的培養(yǎng)基。有些培養(yǎng)基大部分成分為已知化學(xué)結(jié)構(gòu)的營(yíng)養(yǎng)物質(zhì),其中的個(gè)別或少數(shù)成分為未明化學(xué)成分的必須營(yíng)養(yǎng)物,成為半合成培養(yǎng)基,如百日咳菌苗生產(chǎn)用的水解酪素培養(yǎng)基。
根據(jù)用途培養(yǎng)基可分為
1、基礎(chǔ)培養(yǎng)基——這是非常簡(jiǎn)單的培養(yǎng)基,含有提供碳、磷、氮、硫和氫的基礎(chǔ)營(yíng)養(yǎng)物質(zhì)。該培養(yǎng)基用于不需要任何特殊營(yíng)養(yǎng)物質(zhì)生長(zhǎng)的微生物。營(yíng)養(yǎng)肉湯、營(yíng)養(yǎng)瓊脂和蛋白胨水被認(rèn)為是基本培養(yǎng)基。在實(shí)驗(yàn)室中,當(dāng)?shù)谝淮畏蛛x任何未知微生物時(shí),通常首先嘗試在基礎(chǔ)培養(yǎng)基上培養(yǎng)它。
圖2、營(yíng)養(yǎng)瓊脂
營(yíng)養(yǎng)培養(yǎng)基——顧名思義,這種培養(yǎng)基含有額外的營(yíng)養(yǎng)物質(zhì),如血清、血液和蛋黃等。另外添加的營(yíng)養(yǎng)物質(zhì)提供維生素和所有必需氨基酸,支持挑剔微生物的生長(zhǎng)。

圖3、血瓊脂
選擇性培養(yǎng)基——這種培養(yǎng)基支持選擇性微生物的生長(zhǎng)并抑制不需要的微生物的生長(zhǎng)。選擇性培養(yǎng)基可能含有抗生素、化學(xué)物質(zhì),或改變了 pH 值或支持所需細(xì)菌生長(zhǎng)的這些物質(zhì)的組合。
圖4、耐甲氧西林金黃色葡萄球菌選擇性培養(yǎng)基
富集培養(yǎng)基——這種培養(yǎng)基在促進(jìn)所需微生物的生長(zhǎng)方面也非常有選擇性。富集培養(yǎng)基還可能含有抗生素、染料、化學(xué)物質(zhì)或改變了 pH 值或全部的組合。因此,它類似于選擇性媒體。唯一的區(qū)別是他們的身體狀態(tài)。富集培養(yǎng)基為液態(tài)(不含瓊脂),選擇性培養(yǎng)基為固態(tài)(含有瓊脂)。優(yōu)選在使用選擇性培養(yǎng)基之前使用富集培養(yǎng)基。
差異培養(yǎng)基——這種培養(yǎng)基使我們能夠區(qū)分兩種不同細(xì)菌物種的菌落。這是可能的,因?yàn)榫漕伾煌?。差異培養(yǎng)基含有特殊的染料或底物,使細(xì)菌能夠產(chǎn)生不同的菌落顏色。這種培養(yǎng)基在研究細(xì)菌菌落的形態(tài)學(xué)及其分化時(shí)效果最好。
圖5、差異培養(yǎng)基 – EMB 瓊脂上的大腸桿菌特征菌落
厭氧培養(yǎng)基——該培養(yǎng)基專門用于培養(yǎng)厭氧細(xì)菌。培養(yǎng)基含有半胱氨酸或巰基乙酸鹽等還原劑。還原劑利用介質(zhì)中存在的氧氣促進(jìn)厭氧細(xì)菌的生長(zhǎng)。
上述通蔚生物為大家列舉了實(shí)驗(yàn)室實(shí)驗(yàn)的培養(yǎng)基的分類和類型。關(guān)于上述培養(yǎng)基分類并非完全列舉,文中介紹比較常見的培養(yǎng)基分類。如果對(duì)培養(yǎng)基還有不明白,歡迎前來咨詢通蔚顧問,我們?nèi)σ愿盀槟獯?。上海通蔚基礎(chǔ)培養(yǎng)基和細(xì)胞專用培養(yǎng)基,如果您需要培養(yǎng)基,可以和通蔚在線顧問溝通,我們助力您的研究計(jì)劃。